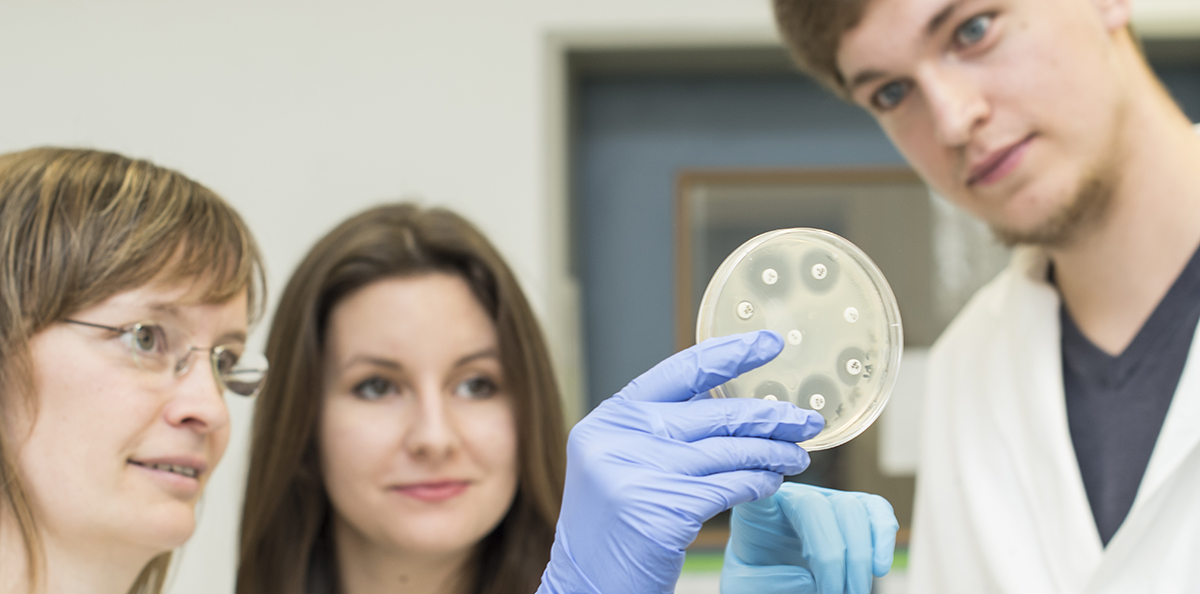

Kontakt
Institut für Mikrobiologie
Felix-Hausdorff-Straße 8
17489 Greifswald
Telefon +49 (0)3834 420 5901
Telefax +49 (0)3834 420 5909
Prof. Dr. Dörte Becher, Geschäftsführende Direktorin
Prof. Dr. André Scheffel, 1. Stellv. Geschäftsführender Direktor
Prof. Dr. Tim Urich, 2. Stellv. Geschäftsführender Direktor
Sekretariat H. Korthase
Das Institut für Mikrobiologie ist in vier Abteilungen gegliedert: Mikrobielle Physiologie und Molekularbiologie unter der Leitung von Susanne Sievers (kommissarisch für Katharina Riedel); Mikrobielle Proteomik - Dörte Becher; Bakterienphysiologie - Tim Urich; und Aquatische Mikrobiologie - André Scheffel. Hinzu kommen die Nachwuchsforschungsgruppen Küstenmikrobiome (Mia Bengtsson) und Mikrobielle Interaktionen (Tjorven Hinzke) sowie die Forschungsgruppe des Emeritus Michael Hecker.